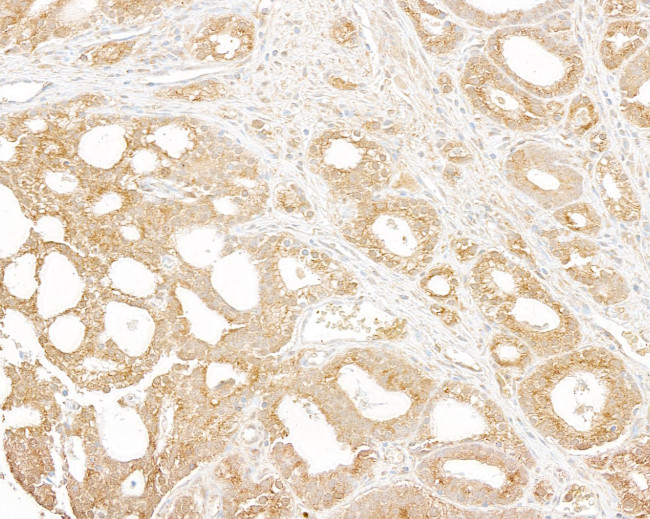
p600 Antibody in Immunohistochemistry (Paraffin) (IHC (P))

Search
Bethyl Laboratories
p600 Polyclonal Antibody
{{$productOrderCtrl.translations['antibody.pdp.commerceCard.promotion.promotions']}}
{{$productOrderCtrl.translations['antibody.pdp.commerceCard.promotion.viewpromo']}}
{{$productOrderCtrl.translations['antibody.pdp.commerceCard.promotion.promocode']}}: {{promo.promoCode}} {{promo.promoTitle}} {{promo.promoDescription}}. {{$productOrderCtrl.translations['antibody.pdp.commerceCard.promotion.learnmore']}}
产品信息
A302-278A
种属反应
宿主/亚型
分类
类型
抗原
偶联物
形式
浓度
规格
纯化类型
保存液
内含物
保存条件
运输条件
产品详细信息
The recommended shelf life for this product is 1 year from date of receipt.
Application Note: For IHC, epitope retrieval with citrate buffer pH 6.0 is recommended for FFPE tissue sections.
靶标信息
E3 ubiquitin-protein ligase which is a component of the N-end rule pathway. Recognizes and binds to proteins bearing specific N-terminal residues that are destabilizing according to the N-end rule, leading to their ubiquitination and subsequent degradation. Together with clathrin, forms meshwork structures involved in membrane morphogenesis and cytoskeletal organization. Regulates integrin-mediated signaling. May play a role in activation of FAK in response to cell-matrix interactions. Mediates ubiquitination of ACLY, leading to its subsequent degradation.
仅用于科研。不用于诊断过程。未经明确授权不得转售。
篇参考文献 (0)
生物信息学
蛋白别名: 600 kDa retinoblastoma protein-associated factor; E3 ubiquitin-protein ligase UBR4; N-recognin-4; p600; RBAF600; retinoblastoma-associated factor 600; retinoblastoma-associated factor 600-like protein; retinoblastoma-associated factor 600; RBAF600; Retinoblastoma-associated factor of 600 kDa; RING-type E3 ubiquitin transferase UBR4; unnamed protein product; zinc finger UBR1-type protein 1; zinc finger, UBR1 type 1
基因别名: 1810009A16Rik; A930005E13Rik; D930005K06Rik; Gm1032; Gm1666; KIAA0462; KIAA1307; mKIAA0462; N28143; p600; RBAF600; UBR4; ZUBR1
UniProt ID: (Human) Q5T4S7, (Mouse) A2AN08
Entrez Gene ID: (Human) 23352, (Mouse) 69116